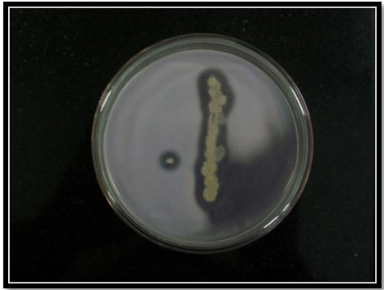

Int J Pharm Pharm Sci, Vol 8, Issue 2, 183-186Original Article
ISOLATION OF ANGIOTENSIN-CONVERTING ENZYME INHIBITOR PRODUCING BACTERIA FROM COW MILK
LIDA EBRAHIMI1, K. G. KIRAN1, K. A. AYUB NAWAZ1, V. SUBASHCHANDRABOSE1, NISSHANTHINI S. DURAIRAJU1, MUTHUSAMY PALANISWAMY2, JAYARAMAN ANGAYARKANNI*1
1Department of Microbial Biotechnology, Bharathiar University, Coimbatore (T. N) 641046, India, 2Department of Microbiology, Karpagam University, Coimbatore (T. N) 641021, India
Email: angaibiotech@buc.edu.in
Received: 31 May 2015 Revised and Accepted: 19 Dec 2015
ABSTRACT
Objective: To evaluate the potential of protease producing organism for the production of Angiotensin I–converting enzyme (ACE) inhibitor by fermentation of various protein substrates.
Methods: Bacterial strains were isolated from cow milk collected in Coimbatore, Tamil Nadu, India by using serial dilution technique, plated on nutrient agar medium. The identity of the strain was ascertained by 16s rRNA gene sequencing method and was submitted to the NCBI GenBank nucleotide database. Various substrates were screened for ACE inhibitor production by the fermentation with the isolated strain.
Results: The isolated coded as BUCTL09, which showed a significant zone of clearance was selected and identified as Micrococcus luteus (KF303592.1). Among the seven substrates, only beef extract fermented broth showed an inhibition of 79% and was reported as the best substrate.
Conclusion: In the search for non-toxic, and economic ACE inhibitors as an alternative to the synthetic drugs, many natural ACE inhibitors have been isolated from a microbial source. In the present study, isolate BUCTL09 was selected for the production of ACE inhibitor from the beef extract. Findings from this study lead us to investigate this potent ACE inhibitor further for its biological properties and to explore the impending efficacy of the ACE inhibitor which may conceivably be developed into a prospective drug.
Keywords: Micrococcus luteus, ACE inhibitor, 16S rRNA gene sequence, Hippuric acid, Beef extract.
© 2016 The Authors. Published by Innovare Academic Sciences Pvt Ltd. This is an open access article under the CC BY license (http://creativecommons.org/licenses/by/4.0/)
INTRODUCTION
Among the bioactive peptides, Angiotensin I–converting enzyme (ACE) inhibitory peptides derived from food proteins have attracted particular attention and have been studied comprehensively for their ability to prevent hypertension. These peptides could be used as a potent functional food additive and represent a healthier and natural alternative to ACE inhibitor drugs. Selecting the proper enzyme to hydrolyze the protein is a key factor in obtaining peptides that exhibit greater levels of ACE inhibitory behavior [1]. ACE is a dipeptide hydrolase that catalyzes both the formation of the potent vasoconstrictor, angiotensin-II (Ang-II), and the deactivation of bradykinin, a vasodilator peptide. Therefore, substances such as synthesized chemical drugs (e. g., captopril) or natural ACE inhibitory peptides can inhibit ACE activity and can cause a drop in blood pressure. These findings have been shown in both hypertensive human subjects and spontaneous hypertensive rats (SHR) [2].
Ang II is the principal biologically active peptide that causes arteriolar vasoconstriction and stimulates aldosterone secretion and thus plays an important role in hydromineral balance. Ang II has a potential role in various aspects of tumor progression and targeting Ang II production, or action could prove useful in anticancer therapy [3]. Researchers hope a better understanding of the angiogenesis process will help them in cancer treatment. There are many reports on ACE inhibitory peptides derived from food proteins, their physiological and pharmacological effects and their prospects for application in preventing hypertension and for therapeutic purposes. This study was intended to isolate protease producing organism for the production of ACE inhibitor by the fermentation of various proteinaceous substrates.
MATERIALS AND METHODS
Isolation of bacteria from milk
Raw unpasteurized milk samples of the cow were collected from the local area of Coimbatore, Tamil Nadu, India. The milk was collected in sterile screw cap tubes and processed within 3 h and used for further studies. Milk samples were serially diluted and were spread plated on nutrient agar medium. The plates were then incubated at 37 ºC for 48-72 h. Individual colonies with typical characteristics of being small (2-3 mm diameter) with entire margins were picked from each plate and transferred to nutrient agar medium. All isolates were initially examined by Gram’s staining, cell morphology, and proteolytic properties.
Screening of protease producing bacteria
The isolates were screened for protease production by gelatin clear zone method using protease specific medium containing KH2PO4 (0.025 g/l), Yeast extract (0.25 g/l), Gelatin (2.5 g/l), NH4HPO4 (0.025 g/l), CaCl2 (0.025 g/l), MgSO4.5H2O (0.0125 g/l) and Agar (3.75 g/l). The diameters of clear zones were measured after 24 h of incubation at 37 °C by flooding the plates with mercuric chloride solution [4]. The isolate which produced the largest zone was selected for further study.
Identification of bacteria
Morphological and biochemical characterizations
Identification of bacteria was performed according to their morphological, cultural, physiological and biochemical characteristics [5]. Gram’s staining, production of catalase, carbohydrate fermentation patterns, growth at 37 °C in nutrient agar medium, methyl red (MR) and Voges-Proskauer (VP) test in MR-VP medium and indole production in tryptone broth as described by Bergey’s Manual of systematic Bacteriology were performed to identify the genus of bacteria.
Molecular characterization of bacteria
DNA isolation
Genomic DNA was isolated from the test organism [6]. Amplification of 16s rRNA gene was done with Universal primers: Forward primer 5’-GAGTTTGATCCTGGCTCAG-3’; Reverse primer 5’-ACGGCTACCT-TGTT ACGACTT-3’ (Chromous Biotech, Bengaluru, India). The amplification of the gene was done as per the table 1. The PCR product was then visualized by running in agarose gel electrophoresis (1%). The amplicon was then sequenced.
Polymerase chain reaction (PCR) amplification of the 16s rRNA gene
The organism was identified with 16S rRNA sequencing method. The PCR product was purified and sequenced by using an automatic sequencer (ABI 3500xl Genetic Analyzer, Chromous Biotech, Bengaluru, India).
Phylogenetic analysis
The sequences obtained were aligned using Chromas Lite Version 2.1.1. The nucleotide Basic Local Alignment Search tool (BLAST) was performed for the amplified sequence using National Center Biotechnology Information (NCBI) BLAST 2.2.28 program. The sequences producing significant alignment were obtained, and distance tree was produced using the BLAST pairwise alignment algorithm. The construction of phylogenetic tree was based on fast minimum evolution method (table 2).
The 16S rRNA gene sequence was obtained and was compared with those available in the GenBank, EMBL and DJB databases using the gapped BLAST 2.0.5 program through the National Center for Biotechnology Information server [7]. Sequences were obtained from the GeBank database and aligned by using the multisequence alignment program Clustal W [8]. Phylogenetic relationships were inferred from this alignment by using programs in MEGA software package. The phylogenetic tree was constructed by using Neighbour-joining method.
Table 1: PCR reaction conditions
PCR reaction mixture 31 cycles and final extension at 72 °C for 10 min |
|||
S. No. |
|||
1. |
10X Taq buffer |
5 µl |
|
2. |
dNTP mix (4 mM) |
5 µl |
|
3. |
Forward primer (5 µm) |
5 µl |
|
4. |
Reserve primer (5 µm) |
5 µl |
|
5. |
Genomic DNA template (100 ng/1 µl) |
5 µl |
|
6. |
Taq DNA polymerase (5 U/µl) |
0.4 µl |
|
7. |
Nuclease-free water |
24.6 µl |
|
8. |
PCR program is mentioned as follows |
||
i. |
Initial denaturation |
96 oC |
5 min |
ii. |
Denaturation |
94 oC |
1 min |
iii. |
Annealing |
48 oC |
1 min |
iv. |
Extension |
72 oC |
2 min |
Table 2: Morphological and biochemical properties of strain BUCTL09
Reactions |
Observation |
Morphology |
Cocci |
Gram’s reaction |
+ |
Catalase test |
+ |
Indole |
- |
Methyl red test |
- |
Voges-Proskauer |
- |
Citrate |
- |
Gas production from glucose |
+ |
Growth at |
37º C |
Growth under aerobic condition |
+ |
Carbohydrate Fermentation |
|
Glucose Lactose Sucrose Mannitol |
+ |
+w |
|
+ |
|
- |
|
TSI agar |
Acids-No H2S |
Skim Milk |
- |
Starch Hydrolysis |
- |
Urease Test |
+ |
Oxidase |
- |
(+) = positive, (+w) = weakly positive, (-) = negative |
|
Screening of substrate for ACE inhibiting peptide production
The selected bacterial culture was used to screen a suitable substrate for the production of ACE inhibitory peptides. Various protein substrates such as beef extract, yeast extract, peptone, milk powder, cow milk, goat milk and buffalo milk were amended in the modified M-9 medium. The cow, goat and buffalo milk were collected from a nearest dairy farm and sterilized by heating at 93 °C for 20 min under constant stirring for the study. Briefly M-9 medium containing MgSO4.7H2O (0.1482 g/l), KH2PO4 (0.3 g/l), FeSO4.7H2O (0.003 g/l), Na2HPO4 (1.28 g/l), NaCl (0.05 g/l), NH4Cl (0.1 g/l), Thiamine (0.03 g/l) and CaCl2.2H2O (0.0456 g/l) was supplemented with different protein sources like beef extract (2 g/l), yeast extract (2 g/l), peptone (2 g/l), commercially available milk powder (2 g/l), cow’s milk (100 ml/l), goat’s milk (100 ml/l) and buffalo’s milk (100 ml/l).
The production medium was inoculated with a loop full of selected bacterial culture from fresh slant (48 h old) and agitated at 150 rpm in a rotary shaker. Overnight grown bacterial cultures were harvested by centrifugation at 4 °C, 8,000 rpm for 20 min. Extracts fermented by different substrates were then screened for ACE inhibition. The protein content of the supernatant was estimated by Lowry’s method [9]. Based on the observation, the chosen substrate was utilized for further studies as ACE inhibitor source.
Assay of ACE inhibition
The ACE inhibitory activity was assayed by the method of Cushman and Cheung with some modifications [10]. Hip-His-Leu (HHL) was dissolved in 50 mM sodium borate buffer (pH 7.0) containing 1N NaCl. Subsequently, 25 µl of 5 mM HHL solution was mixed with 10 µl of beef hydrolysate (the pH of which was adjusted to 7.0) and then pre-incubated for 10 min at 37 °C. The reaction was initiated by adding 10 µl of ACE and the mixture was incubated for 30 min at 37 °C. The reaction was stopped by adding 200 µl of 1N NaCl. The hippuric acid liberated by ACE was extracted with 1 ml ethyl acetate, dissolved by adding 1 ml of the buffer after the removal of ethyl acetate by vacuum evaporation, ant the optical density was measured at 228 nm. The extent of inhibition was calculated using the formula.

Result expressed in percentage
Where
A = the optical density in the presence of ACE and ACE inhibitory component,
B = the optical density without an ACE inhibitory component
C = the optical density without ACE.
RESULTS AND DISCUSSION
Isolation of bacteria from cow milk
Milk samples from cow were collected from local areas of Coimbatore, Tamil Nadu, India and processed for the isolation of proteolytic bacteria. The microbial colonies were counted in raw milk samples by standard plate count. Forty bacterial species were isolated by serial dilution technique by plating on nutrient agar (NA). The colonies in raw milk sample are expected to be little higher than real microflora. This is due to contamination from the animal, especially the exterior of the udder and the adjacent areas; bacteria found in manure, soil and water may be present in milk [11].
Identification of protease producing bacteria
The proteolytic activities of all 40 strains were assayed using gelatin agar, which was observed as the diameter of the clear zone. Among the forty isolates, the isolate coded as BUCTL09 showed the highest proteolytic activity (fig. 1). The best isolate BUCTL09 which produced a maximum zone of clearance was selected for further studies.
The potent bacterial strain was identified based on the morphological and biochemical characterization. The bacteria were Gram positive cocci (fig. 2). The morphological and biochemical characteristics of the test organism are presented in table 2. The morphological and biochemical characterization showed that the selected strain was of genus Micrococcus sp. classified under the family Micrococcaceae [12].
Fig. 1: Protease production by BUCTL09 on gelatin agar plate

Fig. 2: Microscopic view of gram stained BUCLT09
Molecular characterization of selected bacteria
The nucleotide amplified the sequence from 16S rRNA gene was found to have around 781 bp. The 16S rRNA gene sequence of the isolate was compared with available 16S rRNA gene sequence in Gen Bank databases using the BLAST search facility in NCBI. In the present study 16S rRNA gene sequence of BUCTL09 showed 100% similarity with Micrococcus luteus strain. The phylogenetic tree showed the location of isolated strain BUCTL09 close to Micrococcus luteus as depicted in fig. 3.

Fig. 3: Phylogenetic tree showing the position of BUCTL09 phylogenetic tree (Micrococcus luteus)
Screening of substrate for ACE inhibitor production
Extracts from the chosen fermented substrates were screened for ACE inhibition. The ACE inhibition by the bacterial extracts ranged from ~51 to ~79% (table 3). The minimum inhibition being observed in goat milk and the maximum inhibition was exhibited by the beef extract. The increasing order of ACE inhibition was goat’s milk/peptone/commercial milk powder/buffalo’s milk/cow’s milk/ yeast extract and beef extract.
Beef Extract is derived from the infusion of beef and provides an undefined source of nutrients [13], which is a mixture of peptides and amino acids, nucleotide fractions, organic acids, minerals and some vitamins. Beef extract being produced from meat might have some active peptides which might not be present in other protein substrates used which justify the present finding [14]. These facts agree with the present finding that beef extract was the best source of ACE inhibitory peptides and beef extract may be chosen for further ACE inhibitor production.
Table 3: Screening of substrate for ACE inhibitor production
S. No. |
Substrates |
ACE enzyme activity inhibition %∆ |
1. |
Beef extract |
79.67±4.73 |
2. |
Yeast extract |
72.00±3.61 |
3. |
Peptone |
53.33±1.53 |
4. |
Commercial milk powder |
56.67±9.87 |
5. |
Cow’s milk |
62.67±4.04 |
6. |
Goat’s milk |
51.33±2.52 |
7. |
Buffalo’s milk |
61.33±2.08 |
∆Results expressed are means and S. D. of triplicate measurements.
CONCLUSION
Many research groups have combed for ACE inhibitors in microbial sources such as Doratomyces putredinis, Nocardia orientalis, Streptomycetes, Spiculospora, and Actinomadura. In the present study, we isolated and screened a potent ACE inhibitor producing bacteria, Micrococcus luteus (accession number Kf303592). ACE inhibitors are used in the treatment of heart diseases, hypertension, kidney diseases and recent interest has focused on the possible role of these compounds in anticancer therapy [15]. The provocative hypothesis that ACE is might have a protective role in cancer was first suggested by Lever et al. [16] needs to be explored. The search for natural ACE inhibitors as alternatives to synthetic drugs is of great interest to prevent several side effects, and bioactive peptides are one among the best alternatives which can be developed as potential pharmaceutical ACE inhibitors. Currently, many studies are being done to search for more suitable anticancer agents, including ACE inhibitors, from natural products. In the present study, isolate BUCTL09 as M. luteus was selected for the isolation of ACE inhibitors. Findings from this study may open up the possibilities of more alternatives with ACE inhibitory effects with better drug profiles and less adverse side effects.
CONFLICT OF INTERESTS
Declared none
REFERENCES
- Mullally MM, Meisel H, FitzGerald RJ. Identification of novel angiotensin-I-converting enzyme inhibitory peptide corresponding to tryptic fragment of bovine beta-lactoglobulin. FEBS Lett 1997;402:99–101.
- Takano Y. Object shift and scrambling. Natural Language Linguistic Theory 1998;16:817-89.
- Deshayes S, Nahmias O. Angiotensin receptors: a new role in cancer? Trends Endocrinol Metab 2005;16:1016–8.
- Galil AOA. Formation of proteases by Aspergillus fumigatus and Pencillium sp.J King Saud Univ Sci 1992;4:127-36.
- Kandler O, Weiss N. Genus Lactobacillus Beijerinck 1901. 212AL. In: Sneath PHA, Mair NS, Sharpe ME, Holt JG. editors. Bergey’s manual of systematic bacteriology. Baltimore: Williams and Wilkins Co; 1986. p. 1209–34.
- Sambrook J, Fritsch FE, Maniatis T. Molecular cloning: a laboratory manual. 2nd. ed. New York: Cold Spring Harbour; 1989.
- Altschul S, Madden T, Schaffer A. Gapped blast and psi-blast: a new generation of protein database search programs. Nucleic Acids Res 1997;25:3389–402.
- Thompson JD, Higgins DG, Gibson TJ. CLUSTAL W: Improving the sensitivity of progressive multiple sequence alignment through sequence weighting, position-specific gap penalties, and weight matrix choice. Nucleic Acids Res 1994;22:4673–80.
- Lowry OH, Rosebrough NJ, Farr AL, Randall RJ. Protein measurement with the folin phenol reagent. J Biol Chem 1951;193:265-75.
- Cushman DW, Cheung HS. Spectrophotometric assay and properties of the angiotensin-converting enzyme of rabbit lung. Biochem Pharmacol 1971;20:1637-48.
- Garbutt. Essentials of food microbiology. Arnold International edition; 1997. p. 67-72.
- Sharpe ME, Fryer TF, Smith DG. Identification of lactic acid bacteria. In: Gibbs EM, Skinner FA. editors. Identification methods for microbiologists. London: Academic Press; 1979. p. 233-59.
- Cote RJ. Media composition, microbial, laboratory scale. In: Flickinger MC, Drew SW. editors. Encyclopedia of bioprocess technology: Fermentation, biocatalysis, and bioseparation. New York: John Wiley and Sons Inc; 1999;1-5:1640-60.
- Bridson EY, Brecker A. Design and formulation of microbial culture media. Methods Microbiol 1970;3:229-95.
- Lindberg H, Nielsen D, Jensen BV, Eriksen J, Skovsgaard T. Angiotensin converting enzyme inhibitors for cancer treatment? Acta Oncol 2004;43:142–52.
- Lever A, Hole DJ, Gillis CR, McCallum IR, McInnes GT, MacKinnon PL, et al. Do inhibitors of angiotensin-I-converting enzyme protect against risk of cancer? Lancet 1998;352:179–84.